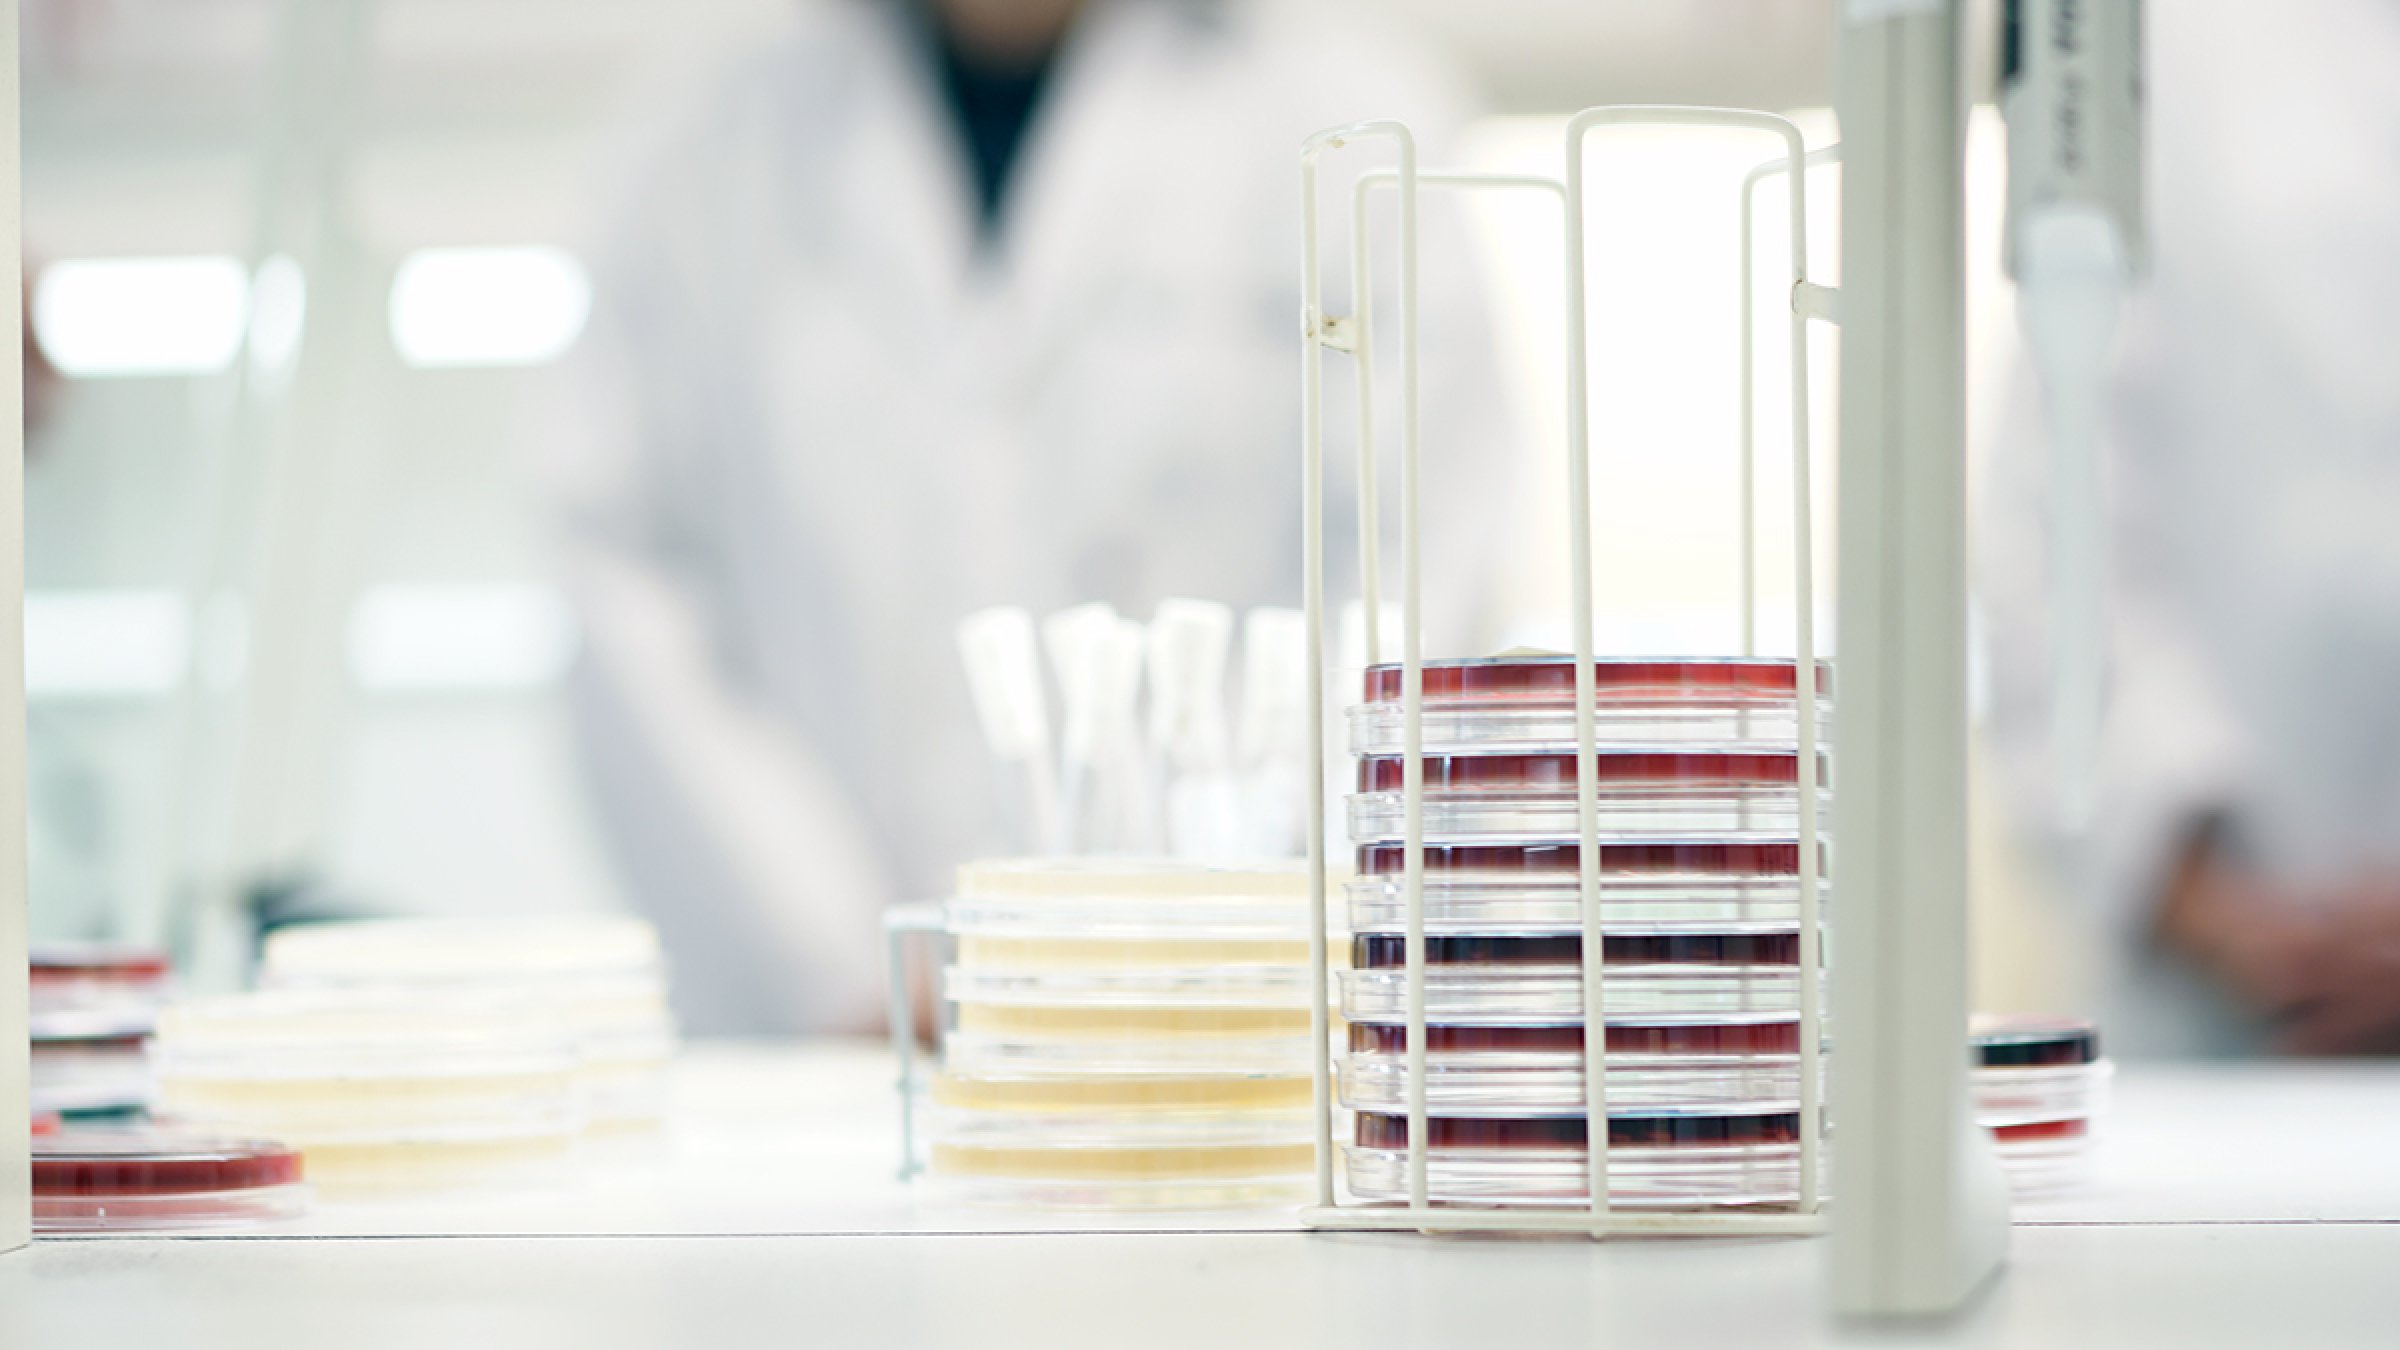

Stadig vanskeligere å behandle matbårne infeksjoner
Dette viser data sammenstilt av Det europeiske smittevernbyrået (ECDC) og Den europeiske myndighet for næringsmiddeltrygghet (EFSA). Rapporten viser at bakteriene Salmonella og Campylobacter, som smitter via mat, har økende forekomst av antibiotikaresistens og dermed blir vanskeligere å behandle.
Rapporten er basert på data samlet inn fra europeiske land i 2018. Den viser at en stor andel av Salmonellabakterier fra mennesker, dyr og mat er resistente mot minst tre antibiotika, det vil si at de er multiresistente. Rapporten viser også at det fra mennesker er enkelte funn av Salmonellabakterier som er resistente mot karbapenemer, et antibiotika regnet som sistelinjepreparat for behandling av bakterieinfeksjoner hos mennesker.
- Funn av karbapenem-resistens i matbårne infeksjoner i Europa er bekymringsfullt, sier Mike Catchpole, sjefsforsker i ECDC. Fortsatt overvåking er viktig for å kunne forbygge spredning av karbapenem-resistente bakterier.
Som fjorårets rapport, viser også denne rapporten at forekomsten av Campylobacter resistente mot fluorokinoloner er svært høy i enkelte land. Fluorokinoloner har til nå vært benyttet ved behandling av alvorlige campylobacterinfeksjoner, og resistens mot disse midlene betyr at de ikke lenger kan benyttes til behandling. Forekomst av resistens mot fluorokinoloner øker også hos Salmonella.
For matproduserende dyr, viser rapporten at trenden går i riktig retning i mange land med en økning i andel indikatorbakterier som er fullt følsomme for de antibiotika det undersøkes for. Flere land kan også vise til en nedgang i forekomst av ESBL/AmpC produserende E. coli i perioden 2015-2018.
- Les mer om rapporten på EFSA sine nettsider
- Her kan du laste ned rapporten
- Her finner du EFSA sitt data visualiseringsverktøy
Overvåking av antibiotikaresistens i Norge
Overvåkingsprogrammet NORM-VET (Norsk overvåkingsprogram for antibiotikaresistens i mikrober fra fôr, dyr og næringsmidler) gir en årlig status for forekomst av antibiotikaresistente bakterier i dyr, fôr og i mat.
Veterinærinstituttet koordinerer NORM-VET på oppdrag for Mattilsynet, samt sammenstiller data på forbruk av antibakterielle midler til dyr.